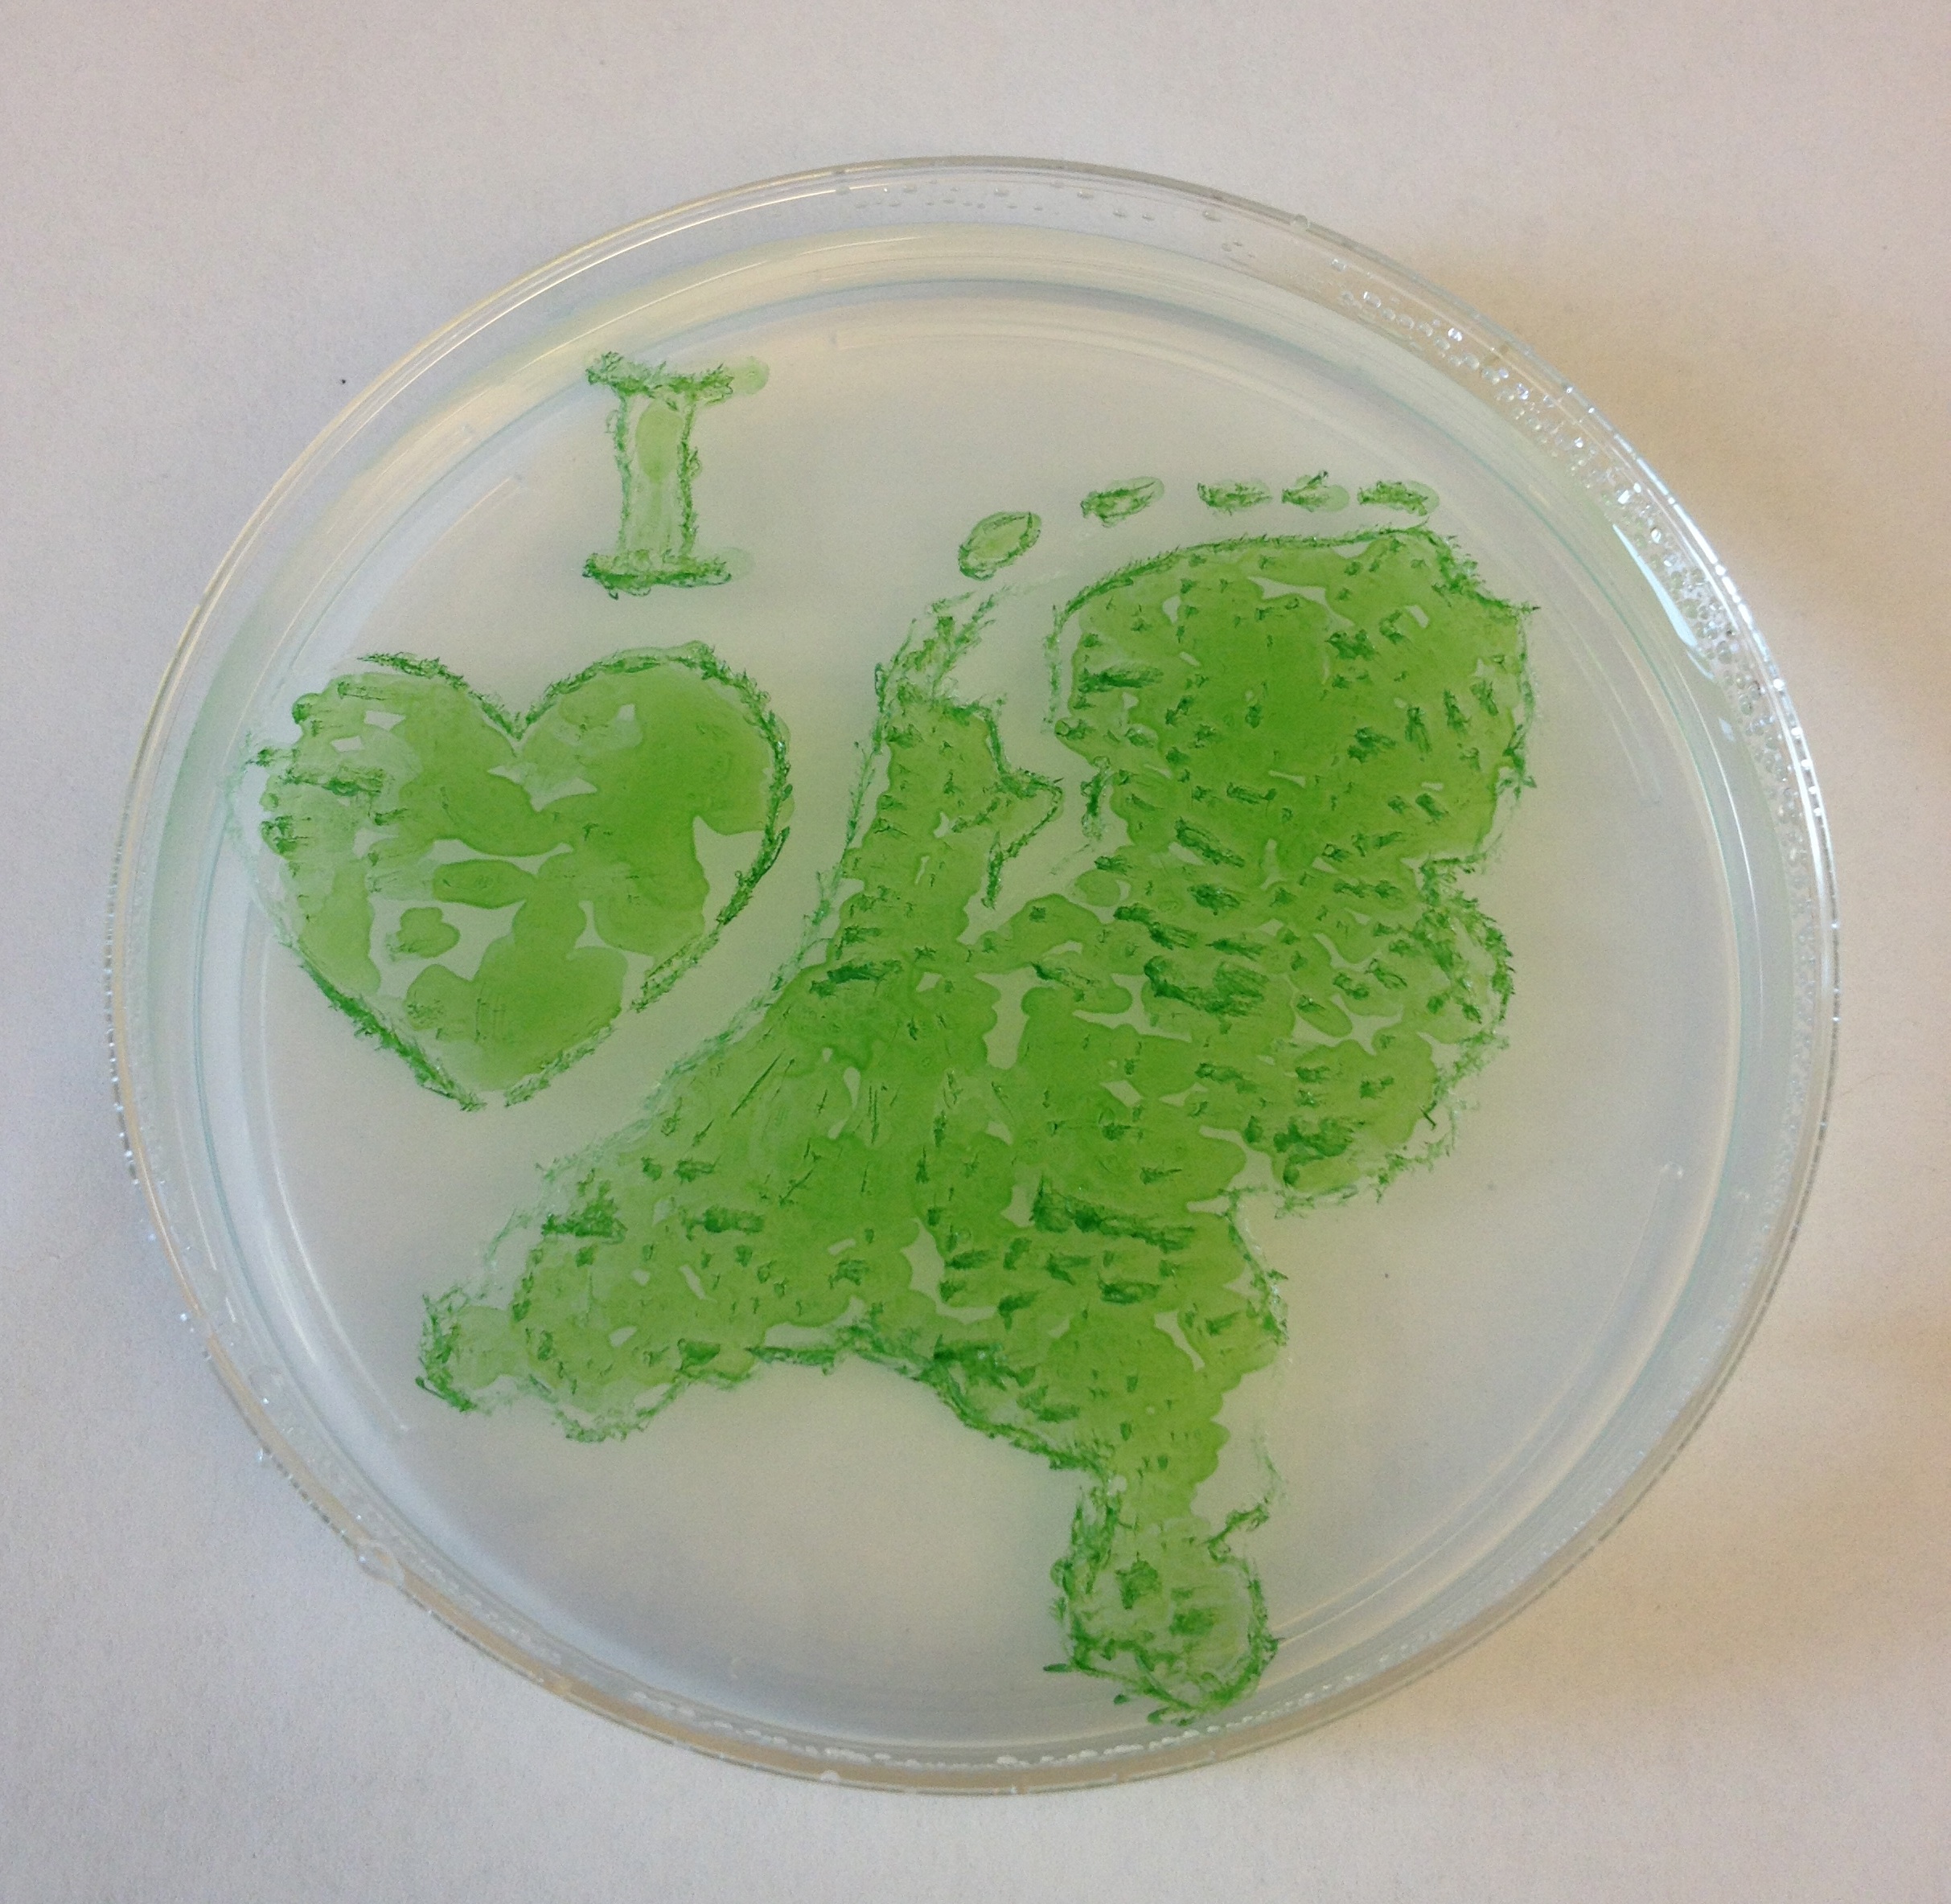

用细菌重启心脏
2018-01-31 10:48:00当心脏病发作时,血液不再循环流回心脏,会导致心脏内部的细胞失去氧气和能量的供给。最终,心脏细胞死亡,心脏也就停止了跳动。科学家们一直有一个想法:如果外科医生能够通过手术来恢复心脏的血液循环,就能够为这些“饥饿的细胞”紧急供氧,那么就可以预防心脏组织的永久性损伤,从而维持心脏的跳动。一个最新的实验用了更加创新的方法:科学家用一种能够进行光合作用的细菌感染大鼠的心脏。这种细菌暴露于自然光下时,会产生氧气,从而提供急需的氧气。

该实验中,科学家使用的细菌是细长聚球藻,这是一种能够像植物一样,利用光能使二氧化碳和水生成氧的细菌。美国斯坦福大学的研究人员使用这种细菌感染了大鼠的心脏肌肉,然后打开大鼠的胸腔,阻止向心脏的主要动脉供血,从而营造能引起大鼠心脏病发作的条件。
之后,他们让大鼠的心脏暴露于实验室的自然光线中,细菌马上开始工作,“心脏病发作”10分钟后,大鼠心脏中的血液氧浓度增加了25倍。

45分钟后,这颗大鼠的心脏工作得很好,要比得了心脏病但没有细菌帮忙的大鼠心脏多泵出60%的血液,也比那些感染了细菌却被放在黑暗中的大鼠心脏多泵出30%的血液。这个显著的差异在研究小组看来,是个巨大的成功:大鼠心脏这种强有力的工作状态,证明有细菌帮助的大鼠心脏一切正常,丝毫没有心力衰竭的症状。而且,在给大鼠心脏做完缝合手术之后的第一周里,研究小组没有在大鼠体内的血液中发现细菌扩散或引起任何毒性作用的证据。
虽然这项新技术在保持啮齿动物心脏功能方面是有效的,但是专家们也指出,将其应用在人类身上是有重大障碍的。一位心脏病专家说:“这真的是一个激进而让我着迷的实验,我也很愿意在我身上做类似的实验。但我们不得不承认,任何一项新的技术,从小动物身体到人类身体的应用都是一条漫长道路,我敢打赌,在我身上做的实验一定会失败!”
不仅如此,这些专家还提出了两个难题:首先,人类的心脏肌肉比老鼠要厚很多,自然光不可能照射到人类心脏内部的细菌。其次,他们并不认为这些细菌对人体无害,研究小组对大鼠免疫反应的检测太粗糙、简单,不能排除人类心脏感染细菌后发生危险的可能。

















